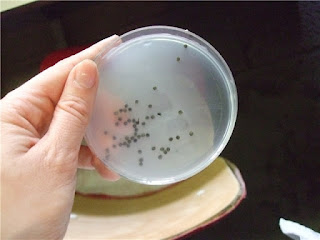

Вчера был очень долгий, но очень интересный день. И таким же, как этот день, будет мой пост - очень длинным, но смею надеяться, интересным. Я постаралась сделать фоторепортаж об одном дне из жизни тех, кто занимается выращиванием рыбы, о моей жизни, собственно. :) Я работаю в научно-исследовательском институте и вчера мы открыли нерестовый сезон для наших рыб. Кому интересно - добро пожаловать в запись! Для удобства остальных запись скрыта под кат.
Yesterday I had a very long, but very interesting day. This post is like my previous day - very long, but I hope very interesting. I tried to make a picture spread about 1 day from a life of those who are busy in fish rearing, about my own life, in fact. :) I work at a research institute and yesterday we started a spwning season for our fish. If you became interested, welcome to this post! For the ease of others I hid this post under the cut.
На фотографиях меня самой очень мало, так как мы с коллегой вдвоём вели весь процесс и были ответственными за его результат, так что либо он на фото, либо я. Но зато процесс передан очень подробно. :)
Место действия - НИИ рыболовства, аквакультуры и ирригации, г.Сарваш, Венгрия; рециркуляционная система.
Время действия - 13 марта 2012 г.
There's no much of me at the pictures, as my collegue and I were together responsible for this process and did it, so, there was either him on the pictures or me. But you can see all in details.
The place: Research institute for fisheries, aquaculture and irrigation, Szarvas, Hungary; a recirculating system.
The time: the 13th of March 2012.
Четыре "детских" бассейна для эксперимента по температурному шоку.
3 "baby baths" for the experiment about temperature shock.
Бассейн для смешивания холодной и тёплой термальной воды, в дальнейшем - для личинок.
A tank for mixing cold and warm thermal waters, later - for larvae.
Yesterday I had a very long, but very interesting day. This post is like my previous day - very long, but I hope very interesting. I tried to make a picture spread about 1 day from a life of those who are busy in fish rearing, about my own life, in fact. :) I work at a research institute and yesterday we started a spwning season for our fish. If you became interested, welcome to this post! For the ease of others I hid this post under the cut.
На фотографиях меня самой очень мало, так как мы с коллегой вдвоём вели весь процесс и были ответственными за его результат, так что либо он на фото, либо я. Но зато процесс передан очень подробно. :)
Место действия - НИИ рыболовства, аквакультуры и ирригации, г.Сарваш, Венгрия; рециркуляционная система.
Время действия - 13 марта 2012 г.
There's no much of me at the pictures, as my collegue and I were together responsible for this process and did it, so, there was either him on the pictures or me. But you can see all in details.
The place: Research institute for fisheries, aquaculture and irrigation, Szarvas, Hungary; a recirculating system.
The time: the 13th of March 2012.
Preliminary stage. 7:45 a.m. We prepare everything we need.
Четыре "детских" бассейна для эксперимента по температурному шоку.
3 "baby baths" for the experiment about temperature shock.
Бассейн для смешивания холодной и тёплой термальной воды, в дальнейшем - для личинок.
A tank for mixing cold and warm thermal waters, later - for larvae.
Система для инкубации икры, аппараты Вейса (Цугера). Вся система собрана за 1,5 недели и работает в полном режиме уже третьи сутки.
A system for fish eggs incubation, Zuger jars. The whole system is made in advance 1.5 weeks ago and has been working for full time for 3 days.
Попутно греется вода для эксперимента.
At the same time water for the experiment is boiling.
Молоко 3,5% для обесклеивания икры. Икра у осетровых очень клейкая и без обработки легко склеится в комок и испортится.
3.5% milk for desticking the eggs. Sturgeon eggs are very sticky and without any treatment can easily stick into a lump and rot.
Второй бассейн для смешивания холодной и тёплой термальной воды. Справа - бассейн для производителей. Как видно, он закрыт сверху, поскольку созревающие рыбы не любят яркое освещение.
The second tank for mixing cold and warm thermal waters. To the right there's a tank for fish breeders. As it can be seen, the tank is covered, because maturing fish don't like bright light.
Оборудование для сбора половых продуктов.
Equipment for stripping eggs and milt.
Первый осмотр рыб. Прошло около 20 часов с момента инъецирования их половыми гормонами для ускорения созревания. Обычно нерест у стерляди проводят в конце апреля.
The first examination of the fish. It is about 20 hours from the moment of sex hormonal injections for inducing the maturation. The usual spawning season for sterlet is in the end of April.
Производители европейской и сибирской стерляди - 12 самок, 12 самцов.
European and Siberian sterlet breeders - 12 females, 12 males.
Проверка готовности рыб к нересту: брюшко должно быть мягким, а из полового отверстия может выделяться икра или сперма.
Checking of fish readiness for spawning: a belly should be soft, there can be discharge of eggs or milt from a genital opening.
Получение спермы - её просто выдавливают из рыбы наружу. Я с бантом :)
Stripping of milt - sperm is pressed out of the fish. I'm with a bow :)
Попутно греется вода для эксперимента.
At the same time water for the experiment is boiling.
Молоко 3,5% для обесклеивания икры. Икра у осетровых очень клейкая и без обработки легко склеится в комок и испортится.
3.5% milk for desticking the eggs. Sturgeon eggs are very sticky and without any treatment can easily stick into a lump and rot.
Второй бассейн для смешивания холодной и тёплой термальной воды. Справа - бассейн для производителей. Как видно, он закрыт сверху, поскольку созревающие рыбы не любят яркое освещение.
The second tank for mixing cold and warm thermal waters. To the right there's a tank for fish breeders. As it can be seen, the tank is covered, because maturing fish don't like bright light.
Оборудование для сбора половых продуктов.
Equipment for stripping eggs and milt.
Первый осмотр рыб. Прошло около 20 часов с момента инъецирования их половыми гормонами для ускорения созревания. Обычно нерест у стерляди проводят в конце апреля.
The first examination of the fish. It is about 20 hours from the moment of sex hormonal injections for inducing the maturation. The usual spawning season for sterlet is in the end of April.
Производители европейской и сибирской стерляди - 12 самок, 12 самцов.
European and Siberian sterlet breeders - 12 females, 12 males.
Проверка готовности рыб к нересту: брюшко должно быть мягким, а из полового отверстия может выделяться икра или сперма.
Checking of fish readiness for spawning: a belly should be soft, there can be discharge of eggs or milt from a genital opening.
Получение спермы - её просто выдавливают из рыбы наружу. Я с бантом :)
Stripping of milt - sperm is pressed out of the fish. I'm with a bow :)
Следующая - самка.
The next one is a female.
Получение икры от самки. Первая порция так же выдавливается.
Stripping of a female. The first portion is also pressed out.
Метод С.Подушки - подрезание яйцевода скальпелем. В результате можно извлечь из рыбы всю икру, при этом сама рыба останется живой и легко регенерирует надрез. Очень важно полностью извлекать созревшую икру из рыбы, поскольку, оставшись внутри, она может начать гнить. Создание же условий для естественного икрометания чрезвычайно сложно и непредсказуемо.
Method of S.Podushka - undercutting of oviducts with a scalpel. As a result, all the eggs can be pressed out from the female, while fish remains alive and can easily regenerate the cut. It is very important to strip all the ovulated eggs from fish, because remaining eggs can begin to rot. Besides, to create favourable conditions for natural spawning is incredibly difficult and unpredictable.
Перерыв на перекус.
Food-break.
Сперму выдавливают в вот такие стаканчики. На каждом стаканчике мы отмечали время получения, подвид стерляди и тип горомональной стимуляции. Сперма может храниться в холодильнике до 24 часов.
Sperm is pushed out into these cups. We mark every cup with a time of stripping, subspecies of sterlet and type of hormonal stimulation. Sperm can be kept up to 24 hours in the fridge.
Снова немного чёрной икры. :)
A little bit more of black caviar. :)
Сперма от разных самцов хранится в разных стаканчиках. Каждый самец может отдать сперму 2-3 раза, самки овулируют икру только 1 раз.
Sperm from different males are kept in different cups. Every male can be stripped 2-3 times, females give ovulated eggs only once.
Вот так идёт икра при правильном проведении подрезания яйцевода.
This is how eggs are stripping when undercutting of oviducts is made properly.
Промывка икры.
Washing of eggs.
Приготовление состава для оплодотворения. Сперма из разных стаканчиков выливается в воду, которая активизирует сперматозоиды.
Preparing of fertilization solution. Sperm from some cups is poured into the water, that activates spermatozoa.
Оплодотворение.
Fertilization
Выкладывание икры на рамочки для эксперимента. Икра легко приклеивается к сеточной поверхности рамы.
Putting of eggs onto the frames for the experiment. The eggs easily stick to a frame's net.
Остальная икра смешивается с разбавленным молоком для обесклеивания.
All the rest of eggs is mixed with diluted milk for desticking.
Икру обесклеивают около 1 часа, трижды меняя раствор молока. В каждом тазу или мискt - икра от одной самки. Все данные об икре (откуда, в какое время), самках и всех процессах записываются.
Eggs are being desticked for approximately 1 hour with 3 changes of milk solution. Every basin or bowl contains eggs from 1 female. All the data about eggs (from whome, at what time), females and all the processes are written down.
Эксперимент на температурный шок. Икра на раме (по 3 рамы для каждой вариации) помещается на 2 минуты в горячую воду (30, 33, 36 и 39 градусов).
Thermal shock experiment. Eggs on a frame (3 frames for every variant) are put into hot water (30, 33, 36 and 39 centigrade) for 2 minuts.
Турецкий коллега только что расставил рамы в бассейны для дальнейшей инкубации.
Turkish colleque has just put all the frames to the tanks for futher incubation.
Полдень. 15 минут перерыва. Рис с овощами и пост на форуме.
Midday. 15 minutes of rest. Rice with vegetables and posting of the forum.
Иду обратно. От моего офиса до цеха примерно 7 минут. Мне вон в то здание за деревьями.
Going back. It takes about 7 minutes to get from my office to a shop. I need that building behind the trees.
Инкубационные аппараты начинают заполняться. Теперь пошла обедать вторая смена.
Incubation jars start to fill. The second shift went for lunch.
Оценка того, как прошло обесклеивание.
Assessment of the desticking results.
Промывка икры от молока.
Washing eggs from milk.
Снова проверка всех производителей.
Checking all the breeders again.
Почти полкило чёрной икры от одной самки. Но эту икру уже нельзя есть, в пищу используют только ту, что ещё не овулировала.
Almost 0.5 kg of black caviar from one female. But nobody should eat this caviar, only unovulated eggs are used for food.
Все процесы идут одновременно и по кругу, много-много раз. Уже начинает сказываться усталость.
All the processes are going at the same time and circulating many-many times. Fatigue is already here, with us.
Аппараты потихоньку заполняются.
Jars are slowly filling.
Оплодотворённая икра в инкабационном аппарате.
Fertilized eggs in the incubation jar.
Самочка сибирской стерляди. На правом плавнике видна видовая метка.
Siberian sterlet female. There's a species marking on the right fin.
Иногда икра выходит вместе с кровью и прочими жидкостями.
Sometimes eggs go out with blood and other liquor.
Немного позирования для истории.
Some pozing for the history.
Время неумолимо. И всего 6 самок позади.
Time is inexorable. And only 6 females are stripped.
Жена коллеги принесла бутерброды и кофе. Все очень довольны. :)
Collegue's wife brought sandwiches and coffee. Everybody is very happy. :)
В икре попался паразитический червь. Он не приносит вреда ни человеку, ни икре.
There was a parasitic worm in eggs. It doesn't do any harm either man, or eggs.
Рыбак счищает с себя слизь и кровь.
A fisherman cleans himself from blood and mucus.
16 часов - конец рабочего дня, но не нашей работы.
4 p.m., the end of the working day but not of our work.
8 порций икры. В каждый из таких аппаратов вода подаётся снизу, что обеспечивает постоянную циркуляцию икры.
8 eggs portions. In these jars water is pumped from the bottom that insures a constant circulating of eggs.
Рабочее место уже в беспорядке.
Our working place is already in mass.
Привезли новые 10 литров молока. Прежнее уже закончилось.
10 new liters of milk were brought. The previous packs had been already finished.
Второй ряд инкубаторов. Всего их 16 штук.
The second row of incubatation jars. There're 16 in total.
18 часов. Последняя проверка рыб перед ночной сменой. Созревших производителей нет.
6 p.m. The last check of fish before a night shift. There are no any more mature breeders.
Всё готово для возможного продолжения оплодотворения икры ночью. Все уже ушли.
Everything is prepared for a possible night egg fertilization. Everybody has already gone.
Мы с коллегой уходим последние. Уже совсем темно.
My collegue and I are the last ones who leave. It is very dark outdoors.

Да-а! Рукоделие, викторианство, вкусная еда и - наши профессии, наши должности, наша работа! Никогда даже не подозревала, что такое бывает: люди(!) открывают нерестовый сезон для рыб. И что икру молоком поливают, чтоб не склеивалась... И множество всего прочего... Спасибо за экскурсию. Впечатлений много.
ОтветитьУдалитьНу, о рыбах и рыбоводстве вообще много предубеждений и слухов. Я рада, что всё увиденное подарило много впечатлений!
УдалитьСветлана, мне было очень интересно прочитать о вашем дне! Сама бывала на рыборазводнях, раньше был большой интерес к содержанию и разведению рыбы. Было познавательно почитать и посмотреть как проходит сцеживание икры и оплодотворение, это столько сил требует.
ОтветитьУдалитьПожалуйста!
УдалитьОчень интересный пост, только наверно сказывается моя усталость и я запуталась :( А зачем сперма в разные стаканчики если потом вы ее сливаете вместе? (или я что-то напутала, или часть спермы вы оставляете для анализа?)
ОтветитьУдалитьправильно ли я поняла последовательность - добыча материала (икры и спермы), промывание икры, оплодотворение, часть оплодотворенной икры идет для эксперимента (температурный шок) а часть на инкубацию (в этот сложные аппарат). Просто я никогда не задумывалась как размножают стерлядь в неволе, а этот пост прямо-таки заинтересовал (да и сказывается научная работа последние 6 лет)
Сперма сливается в разные стаканчики, чтобы отличать, какая от какого самца - она бывает разного качества, более водянистая или, наоборот, более концентрированная. При оплодотворении икры нужна икра от 2-3 самцов для обеспечения генетического разнообразия.
УдалитьПоследовательность верная. Инкубация длится 5-7 дней, в зависимости от температуры, потом появляются личинки. За время инкубации икру дважды в сутки обрабатывают йодовыми препаратами для профилактики заболеваний.
Очень интересный и трудоемкий процесс однако. Я где-то краем уха слышала, что в калифорнии тоже есть ферма подобного типа... спасибо за пост. Я что-то мало комментирую у тебя в последн. время, но посты просматриваю. Ты молодец, отличный блог!
ОтветитьУдалитьСпасибо! На самом деле, ферм такого рода очень много: половина всей продаваемой рыбы выращена искусственно, т.е. так или иначе, процесс похож на этот. Это вроде птицефермы или свинофермы :)
УдалитьОй, прямо как на экскурсии побывала. Очень интересный репортаж. Рыб только жалко. А вот у тех рыб, у которых икру выдавили, может еще икра появиться? Или они уже не детородные?
ОтветитьУдалитьСейчас это наиболее щадящий метод получения икры. Раньше самок просто убивали и вспарывали брюхо. Самки осетровых созревают и нерестятся каждые 2-3 года, самцы - каждый год. Мы держим это стадо уже несколько лет, и оно каждый год участвует в нересте.
Удалитьочень интересно! это как часто так по 18часов вы там работаете?
ОтветитьУдалитьнаверно у вас там очень сильный рыбий запах в цехе?
а куда эту рыбу потом, на продажу?
Запах рыбы, если свежей, давно уже стал привычным. :) В таком режиме работаем редко, только когда нерест, обычно весной.
УдалитьУ нас НИИ, так что рыбу мы не продаём практически - выращиваем до 10 г и выпускаем либо передаём на другие хозяйства. Но на фермах, которые держат рыбу для продажи, этим же методом работают.
Не легкая у вас работа, но интересная! :)))
ОтветитьУдалитьНадо же, а я думала, что икра - это уже зародыши маленьких рыб, а оказывается, что из нее рыбки бы никогда не вылупились :)))
Рыбья икра - это как человеческая яйцеклетка, в ней генетический материал, желток и оболочки. Без оплодотворения из икры никто вылупится не может. :)
УдалитьПотрясающе интересно! Спасибо! на одном дыхании просмотрела!:)
ОтветитьУдалитьА если икра с кровью выходит - рыба жива остается?
А когда появятся рыбки? Потом они где будут выращиваться и что с ними дальше будет, вы их в природные условия выпускаете?
Если икра с кровью, то рыба тоже обычно жива остаётся. Это нестрашно. Рыбки появятся у нас через 4,5 суток, но обычно через 5-7 суток для этого вида рыб, в зависимости от температуры воды.Сначала появятся личинки, которые будут питаться за счёт желтка. Постепенно желтое будет уменьшаться, а они научатся питаться внешним кормом: природным или сухим искусственным. Личинок и молодь до 10 г мы будем держать в бассейнах в этом же цехе. А осенью выпустим в пруды или передадим а другие хозяйства, где больше мощность - чем больше рыба, тем больше места и воды ей требуется.
УдалитьСпасибо:)) Оч.интересно!!!
УдалитьСпасибо за рассказ! не представляла себе этого процесса вообще.
ОтветитьУдалитьПожалуйста!
УдалитьСветочка очень интересный рассказ, прочла на одном дыхании! Ты великий корреспондент и литератор! (Аньес)
ОтветитьУдалитьЗасмущала совсем )
УдалитьБольшое спасибо за интерессный рассказ! Большое уважение вызывает Ваша работа, я сам немного занимаюсь этой темой, но с икры малька пока не получал, тем более с икрой не работал. Вам успехов в научных разработках, а вашим питомцам комфортного проживания и здоровья!!!
ОтветитьУдалитьУдачи Вам!!!
Светлана, хорошая, иллюстрированная статья! Но, наверняка, этим не ограничивается ваша научно-рыбоводная деятельность, хотелось бы увидеть дальнейшую судьбу потомства...
ОтветитьУдалитьИ разрешите несколько вопросов. Перед получением половых продуктов, у производителей была зимовка при естественном температурном режиме? если нет, то какой продолжительности была зимовка и при какой температуре? и где выращивается рыба (УЗВ, пруды, прямоток с естественным температурном режимом)?
Спасибо и вам за визит! Сейчас вся молодь содержится в прудах института и останется там на зимовку в том числе. Гибриды находятся отдельно в бассейновой системе проточного типа на естественном темп.режиме (воды берётся из той же реки, которая снабжает водой и пруды).
УдалитьЗимовка производителей проводилась в прудах.
Светлана, спасибо за интересный рассказ! и я вспомнила своё далёкое прошлое, когда занималась микробиологией:) научная атмосфера, как это было интересно...
ОтветитьУдалитьОчень интересно!!! Прочитала с удовольствием!
ОтветитьУдалить